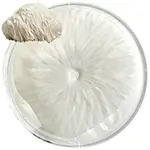
50-pieces-disposable-food-cover-Lions-Mane-Mushroom-petri-dish-or-agar-plate-mycelium-grow-mycology

| Image | Type |
|---|---|
![]() | Whole Shiitake Dried View Product |
![]() | Sliced Dried Shiitake View Product |
![]() | Oyster Mushroom Dried View Product |
![]() | Lion’s Mane Mushroom Dried View Product |
![]() | Cordyceps Militaris Dried View Product |
![]() | Cordyceps Sinensis Dried View Product |
![]() | Chaga Mushroom Dried View Product |
![]() | Chaga Chunks Dried View Product |
![]() | Whole Reishi Dried View Product |
![]() | Sliced Dried Reishi View Product |
![]() | Morel Mushroom Dried View Product |
![]() | Whole Black Truffle Mushroom Dried View Product |
![]() | Black Truffle Mushroom Slices View Product |
![]() | Maitake Mushroom Dried View Product |
| Image | Type |
|---|---|
![]() | Lion’s Mane Mushroom Powder View Product |
![]() | Shiitake Powder View Product |
![]() | Oyster Mushroom Powder View Product |
![]() | Chaga Mushroom Powder View Product |
![]() | Cordyceps Sinensis Powder View Product |
![]() | Cordyceps Militaris Powder View Product |
![]() | Reishi Powder View Product |
![]() | Turkey Tail Mushroom Powder View Product |
![]() | Maitake Powder View Product |
| Image | Type |
|---|---|
![]() | Black Truffle Mushroom Chips View Product |
![]() | Chili Garlic Mushroom Chips View Product |
![]() | Spicy Barbeque Mushroom Chips View Product |
![]() | Salt And Pepper Mushroom Chips View Product |
![]() | Sour Cream And Onion Mushroom Chips View Product |
![]() | Parmesan Cheese Mushroom Chips View Product |
| Image | Type |
|---|---|
![]() | Lion’s Mane Mushroom Fresh View Product |
![]() | Shiitake Fresh View Product |
![]() | Oyster Mushroom Fresh View Product |
Gourmet Mushroom
Spore Syringe
| Image | Type |
|---|---|
![]() | Shiitake Spore Syringe View Product |
![]() | Lion’s Mane Spore Syringe View Product |
![]() | Oyster Mushroom Spore Syringe View Product |
| Image | Type |
|---|---|
![]() | Sterilized Liquid Culture View Product |
![]() | Shiitake Liquid Culture View Product |
![]() | Lion’s Mane Liquid Culture View Product |
![]() | Oyster Mushroom Liquid Culture View Product |
| Image | Type |
|---|---|
![]() | Lion’s Mane Mushroom Grain Spawn View Product |
![]() | Shiitake Grain Spawn View Product |
![]() | Oyster Mushroom Grain Spawn View Product |
| Image | Type |
|---|---|
![]() | Sterilized Wheat Berry View Product |
![]() | Sterilized Rye Berry View Product |
![]() | Sterilized Millet View Product |
| Image | Type |
|---|---|
![]() | Sterilized Coco Coir Substrate View Product |
![]() | Pasteurized Manure Substrate View Product |
![]() | Sterilized Hardwood Substrate View Product |
![]() | Pasteurized Mushroom Casing Layer View Product |
![]() | Spent Mushroom Substrate View Product |
Grow Tek
| Image | Type |
|---|---|
![]() | Brown Rice Flour – BRF Jar View Product |
| Image | Type |
|---|---|
![]() | Shiitake Spore Print View Product |
![]() | Lion’s Mane Spore Print View Product |
![]() | Oyster Mushroom Spore Print View Product |
| Image | Type |
|---|---|
![]() | Lion’s Mane Petri Dish View Product |
![]() | Shiitake Petri Dish View Product |
![]() | Oyster Mushroom Petri Dish View Product |
![]() | Pre-Pour Petri Dish View Product |
![]() | Transparent Petri Dish View Product |
| Advanced Petri Dish View Product |
| Image | Type |
|---|---|
| Wheat Berry View Product | |
| Rye Berry View Product | |
| Brown Rice View Product | |
| Seed View Product | |
| Oat View Product | |
| Popcorn View Product |